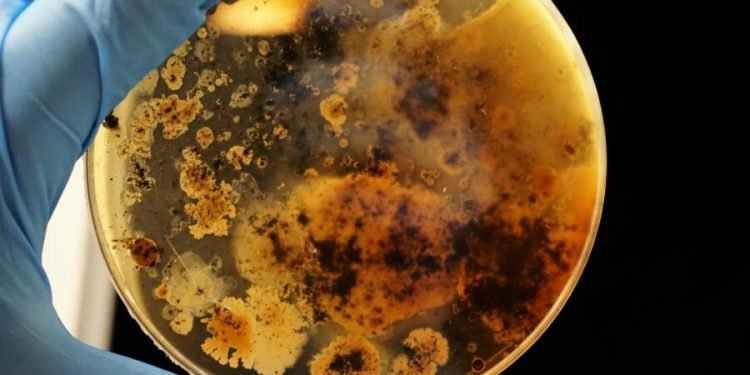
As Food Recalls Mount, Experts Urge Food Safety ‘Culture’ Change

Current meals recollects illustrate a “disturbing” lack of meals security tradition, based on Dr. Vanessa Coffman. One in six People fall sick from foodborne sickness yearly as of late.
Making issues worse, the general public is usually left confused by food-recall press releases stuffed with difficult-to-understand jargon, Coffman added.
“Customers aren’t getting the actionable info they want, within the format they want it in, to successfully take away hazardous merchandise from their houses,” Coffman, director of the Alliance to Cease Foodborne Sickness, advised The Meals Institute. “Except a recall is giant, multistate, and will get picked up by the information, it usually goes unnoticed; shoppers must be checking a number of authorities web sites day-after-day to get the complete scoop.”
Lately, a complete of 97 shoppers throughout six states have been left sick by E.coli, in an outbreak presumably tied to contaminated lettuce makes use of in sandwiches bought at Wendy’s eating places, reported HealthDay. By means of August 23, there have been 152 meals security recollects issued by the USDA.
Moreover, of recollects issued by the USDA’s Inspection Service, 24 have been categorized as Class I – which means they’re deemed “most regarding” as a result of they’re associated to merchandise “prone to trigger severe hurt or demise.”
MISCONCEPTIONS PERSIST
It’s clear, based on Coffman, that meals producers, suppliers, and co-packers must strengthen their inner meals security cultures and stress that initiative to workers. Consequently, the Alliance – which works in collaboration with meals security consultants on the likes of Kellogg, Amazon, and Costco – not too long ago distributed a Meals Security Tradition Toolkit for smaller corporations.
Although the variety of recollects hasn’t essentially elevated in recent times (there have been 63 FSIS-related recollects in 2021, in comparison with 131 in 2019, for instance), Coffman feels the recollects might be reported to the general public extra successfully.
She additionally feels there are a number of misconceptions on the subject of meals recollects. For instance, many shoppers really feel most recollects merely aren’t that necessary – a difficulty worsened, Coffman stated, by the truth that most recall press releases characteristic phrases like “voluntary recall” and “out of an abundance of warning.”
“The (false impression) that issues me essentially the most is that recollects aren’t necessary they usually received’t affect you,” Coffman stated.
POSSIBLE SOLUTIONS
Coffman feels meals corporations want to make use of technological advances like apps and push notifications to alert the general public of recollects. And, she added, recall notices ought to ideally embody detailed directions which are simpler for shoppers to know.
“At the moment, shoppers should have a look at loads of codes, and non-uniform ‘best-by’ dates, to establish (recalled) merchandise,” Coffman defined. “This causes confusion, resulting in shoppers consuming probably harmful meals or, alternatively, throwing away completely high quality gadgets.”